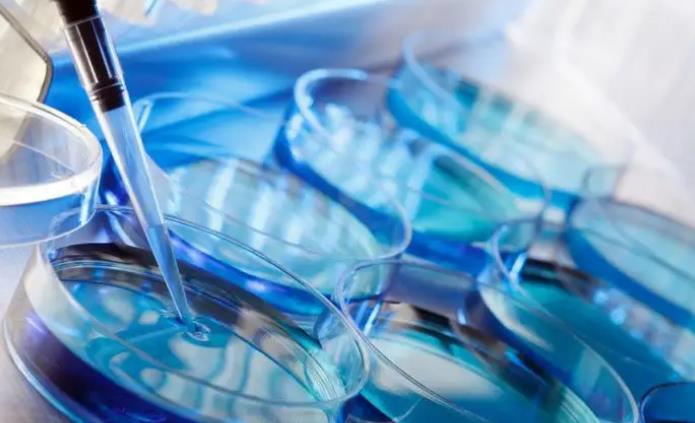

做试管婴儿内膜不好是实施试管婴儿的重大困难之一。一般来说,实施试管婴儿的要求之一就是内膜规格要求。如果内膜不规范,则实施试管婴儿就变得困难,对耗费时间和金钱也会有影响的。那么,做试管婴儿内膜不好怎么办?
首先,可以进行相应的在线检查,及早检测内膜不良情况,以便及时采取措施。如果内膜不规范,则可以考虑是否可以进行入周期试管。此外,做试管婴儿内膜不好之后,还可以考虑移植,以便最大限度地保持胚胎的健康发育,提高最终成功的可能性。
那么,做试管婴儿内膜不好,可以移植吗?一般来说,内膜不规范都可以移植,不过移植后的胚胎成功率没有相应规格内膜的胚胎成功率要低。虽然做试管婴儿内膜不好,但只要内膜厚度超过3mm,或者超过2mm就可以继续移植,还可以考虑腔内支持技术(ISCI)。
另外还要考虑子宫内膜不良的原因。通常来说,内膜不良的原因可能是多方面的。比如,受孕期外环境的持续刺激可能会导致内膜受到破坏,或者也可能是受激素失衡,得不到平衡的情况下内膜的发育受到影响。
做试管婴儿内膜不好会怎么样呢?大多数情况下,内膜不良会影响实施试管婴儿的效果。由于实施试管婴儿需要在适当的技术环境下进行,所以如果内膜不良,则很难创造一个适合实施试管婴儿的环境,从而影响胚胎的生长发育。此外,内膜不良也会影响试管婴儿成功的可能性,如果内膜不好,成功率就会相应下降,有可能导致移植失败。
内膜不好能做试管婴儿吗?如果内膜超过2~3mm,则可以使用ISCI技术(促性腺激素引爆)进行移植,并且应用此技术成功率也非常高。如果内膜小于2mm,成功率就会大打折扣。但是,对于子宫内膜不好的女性,也可以尝试做试管婴儿,只要把其他因素(比如健康情况,胚胎质量等)控制好,还是有可能获得非常理想的结果的。
.jpg)
多囊卵巢综合征(PCOS)是一种常见的不孕症,其中一个重要的病理特征是多囊卵巢的形成,即多腔房的卵巢的存在。该病的发病率高达10%-15%,特别是在20-35岁的妇女中,表现为月经紊乱、不孕症或复发流产等。
.jpg)
试管婴儿促排卵泡少怎么办?增加卵泡数量的有效措施大揭秘,试管受精技术是一种辅助生殖技术,可以帮助许多不孕夫妇实现他们的生育梦想。然而,一些女性在试管受精前发现卵泡数量很少,这对她们来说是一个非常沉重的打
.jpg)
我家孩子现在已经1岁多了,之前给喝的3段奶粉,我感觉营养成分不够好,所以打算给换一款不同品牌的奶粉给宝宝,但是不同品牌的奶粉转奶也太不容易了,我之前按照自己的方法来操作,宝宝却不怎么喝,不管怎么哄就喝那
.jpg)
试管婴儿全流程解析帮助对试管宝宝有更深入的了解!试管受精是一种辅助生育技术,可以帮助许多不孕夫妇实现他们的生育梦想。但这个过程对许多人来说仍然充满了神秘和怀疑。接下来小编将给大家揭示试管受精的所有细节和
.jpg)
性激素六项报告单是一种用来检测性激素水平的检查单,它是由复合激素、单纯激素和其他因子组成的。复合激素包括睾酮、雌二醇、孕酮、甲状腺素等,而单纯激素则包括睾丸素、雄激素、孕三烯醇等。其他因子包括性腺素、